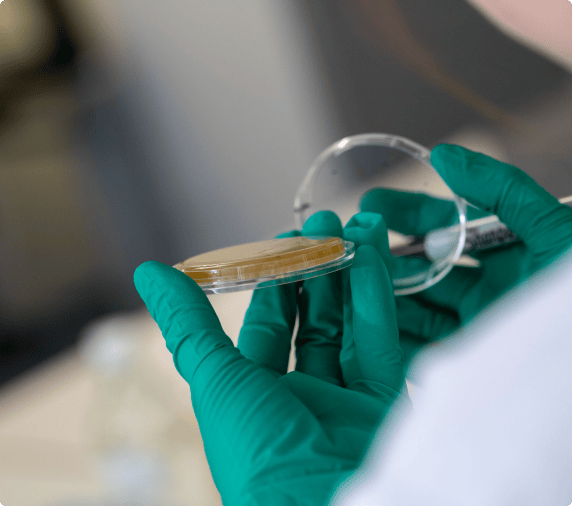
Petri dish in lab

With our 25+ years of experience and expertise, we can and have delivered on programs from early phase all the way through commercial GMP manufacturing. With over 8,000 patients dosed with our lentiviral vectors, we are trusted by a broad range of clients.
Our Services
We provide a flexible service offering designed to support you wherever you are in your development journey – whether you are in early phase or ready for commercial GMP manufacturing.
Construct & Plasmid Design
Analytical Method Development
Process Development
GMP Cell Banking
GMP Manufacturing
QA Release
Stability Studies
Regulatory Support
The LentiVector™ platform
The LentiVector™ platform is the world’s first lentiviral-based gene delivery system to be commercially approved. The platform can provide:
Optimised processes producing higher titers of drug substance per batch than traditional processes
Reliable commercial quality, notably supporting the first FDA approved CAR-T cell therapy
Best-in-class perfusion bioreactor process that offers superior yield and quality
An established serum-free suspension bioreactor process
Automated product-specific design of experiment
Minimal 3rd generation vector systems with key safety features
Expertise with different lentiviral-based vectors (HIV, SIV, EIAV) and using various pseudotypes to target specific cells
Large suite of in-house analytical methods recognised by regulatory bodies for an accelerated GMP batch release
Access to unique chemical and mRNA enhancers to boost productivity
4th generation lentiviral vector system offering higher quality and potency
Optimised cell lines for a scalable manufacturing process
What we do
We know the challenges for lentiviral vector manufacturing, and we are ready.
Access to unique technologies
Our flexible licensing structure gives you access to unique technologies, along with the support you need to develop and deliver groundbreaking new lentiviral-based products. Achieve your objectives more easily using our advanced and reliable technologies:
See our other services
We partner with cell and gene therapy companies to provide innovative, end-to-end adeno-associated virus (AAV) process development and manufacturing services.

Discover our latest case study on improving manufacturing conditions with DOE studies for optimal lentiviral vector production.
Stay in touch
Subscribe to receive OXB's latest news, events and insights
Stay in touch - Subscribe









